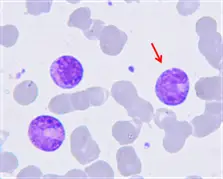
圖片

110年:(醫檢)血液(2)
箭頭所指的細胞最有可能是下列何者?
AMyeloblast
BPromyelocyte
CMetamyelocyte
DLarge granular lymphocyte
詳細解析
本題觀念:
本題考查白血球成熟過程中的形態學鑑別 (Morphological differentiation),特別是針對骨髓球系 (Myeloid series) 各階段細胞核型態與細胞質顆粒特徵的辨識。
影像分析:
在提供的血液抹片影像中:
- 背景:可見成熟紅血球 (RBC),作為大小對照。
- 箭頭所指細胞特徵:
- 細胞大小:明顯大於周圍的紅血球 (約 1.5-2 倍),推測直徑約 12-18 µm。
- 細胞核:核呈現明顯的凹陷狀 (Indented) 或 腎形 (Kidney-bean shaped)。這不是圓形 (排除 Myeloblast, Promyelocyte, Myelocyte),也尚未變成帶狀或分葉狀 (排除 Band, Segmented neutrophil)。
- 染色質 (Chromatin):核染色質呈現粗糙、凝聚 (condensed/clumped) 的現象,而非原始細胞的細緻網狀,且未見核仁 (Nucleoli),顯示細胞已具有一定成熟度。
- 細胞質:細胞質豐富,染成淡粉色或淡紫色,含有細緻的顆粒 (Specific granules),而非粗大的嗜天青顆粒 (Primary granul
...(解析預覽)...

升級 VIP 解鎖圖文解析